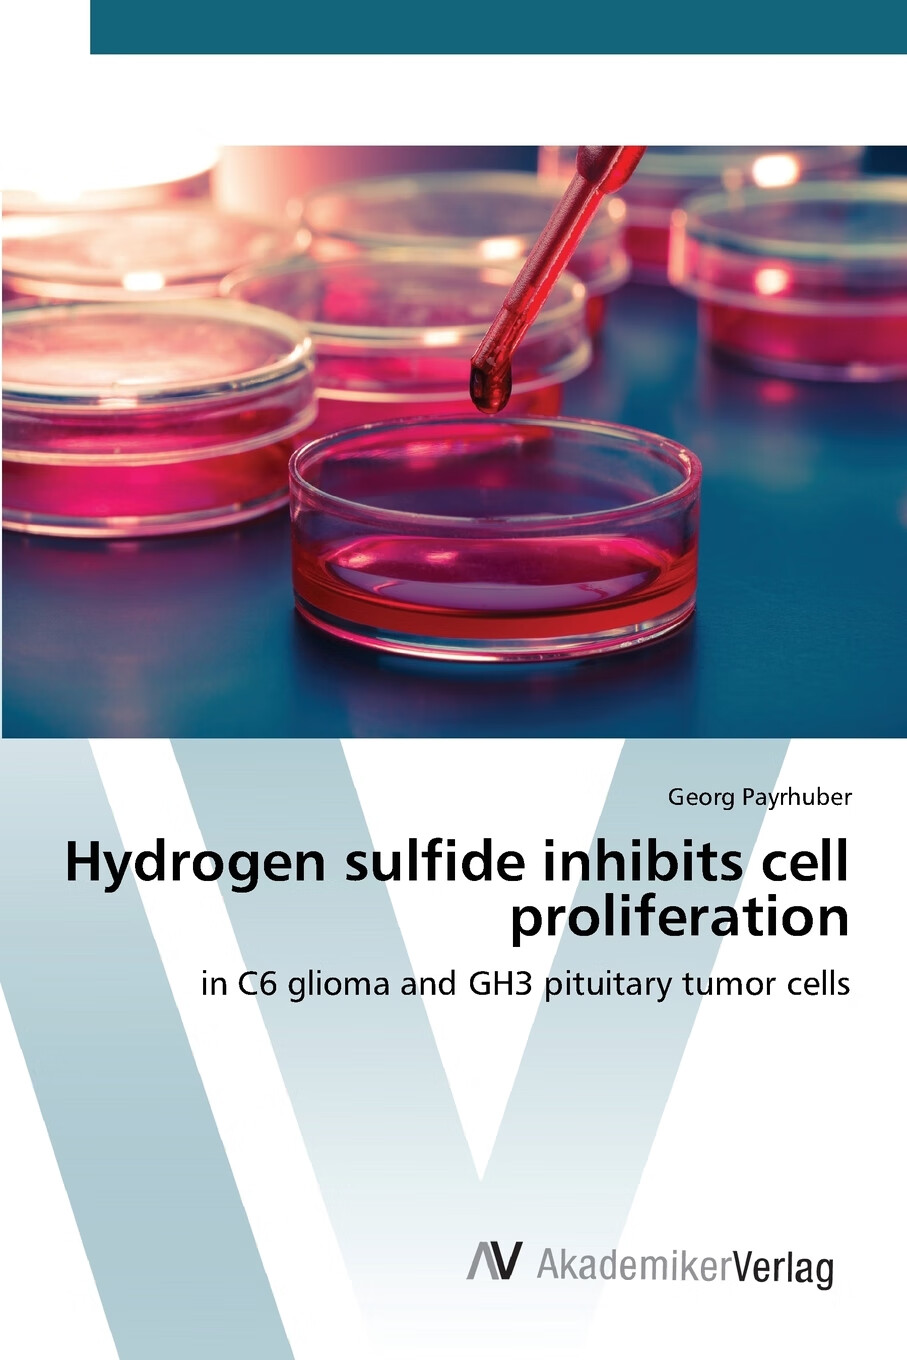
【预售 按需印刷】hydrogen sulfide inhibits cell proliferation

hydrogen sulfide

海外直订hydrogen sulfide: chemical biology basics, detection
图片尺寸800x800
【预订】hydrogen sulfide in plant biology 9780323858625
图片尺寸266x400
【预售】hydrogen sulfide in redox biology part b
图片尺寸331x499
【预售 按需印刷】hydrogen sulfide inhibits cell proliferation
图片尺寸907x1360
预订 hydrogen sulfide and plant acclimation to abiotic stresses
图片尺寸330x499
【预售】hydrogen sulfide in redox biology part a
图片尺寸230x346
预售 按需印刷 hydrogen sulfide management in petroleum industry
图片尺寸907x1360
h2s portable hydrogen sulfide detector - buy hydrogen sulfide
图片尺寸750x750
hydrogen sulfide
图片尺寸144x144
【4周达】hydrogen sulfide and reactive oxygen species
图片尺寸800x800
hydrogen sulfide: role in ion channel and transporter modulation
图片尺寸570x409
【预订】hydrogen sulfide in redox biology part b 9780128015117
图片尺寸500x500
chemistry, biochemistry and pharmacology of hydrogen sulfide
图片尺寸330x500
海外直订hydrogen sulfide and its therapeutic applications 硫化氢
图片尺寸800x800
硫化氢检测
图片尺寸435x390
decreased hydrogen sulfide formation in beer production
图片尺寸1904x2717
预订 高被引hydrogen sulfide and its therapeutic applica
图片尺寸333x499
cadmium sulfide
图片尺寸954x636
【预订】hydrogen sulfide and its therapeutic applications
图片尺寸500x500
p>无机化学中, b>硫化物(sulfide) /b>指 a href="#">电正性 /a>较强
图片尺寸731x607